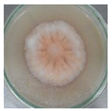
Blsf 18 00064 i001 Blsf 18 00064 i001
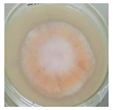
Blsf 18 00064 i002 Blsf 18 00064 i002
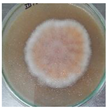
Blsf 18 00064 i003 Blsf 18 00064 i003
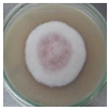
Blsf 18 00064 i005 Blsf 18 00064 i005
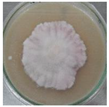
Blsf 18 00064 i006 Blsf 18 00064 i006
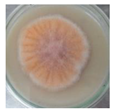
Blsf 18 00064 i007 Blsf 18 00064 i007
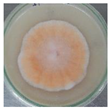
Blsf 18 00064 i008 Blsf 18 00064 i008
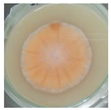
Blsf 18 00064 i009 Blsf 18 00064 i009
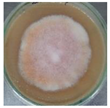
Blsf 18 00064 i010 Blsf 18 00064 i010
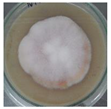
Blsf 18 00064 i011 Blsf 18 00064 i011
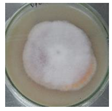
Blsf 18 00064 i012 Blsf 18 00064 i012
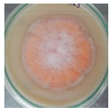
Blsf 18 00064 i015 Blsf 18 00064 i015
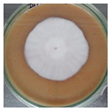
Blsf 18 00064 i017 Blsf 18 00064 i017
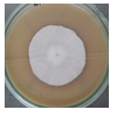
Blsf 18 00064 i018 Blsf 18 00064 i018
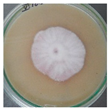
Blsf 18 00064 i020 Blsf 18 00064 i020

Effect of Carbon, Nitrogen and Salt Sources on the Growth of Monascus purpureus in Quinoa (Chenopodium quinoa)-Based Culture Media †
Abstract
1. Introduction
2. Materials and Methods
2.1. Inoculum Production
2.2. Growth Experiment
2.2.1. Preparation of Culture Media and Inoculation
2.2.2. Growth Rate
2.3. Statistical Analysis
3. Results and Discussion
4. Conclusions
Author Contributions
Funding
Institutional Review Board Statement
Informed Consent Statement
Data Availability Statement
Acknowledgments
Conflicts of Interest
References
- Hong, M.Y.; Seeram, N.P.; Zhang, Y. Heber D. Anticancer effects of Chinese red yeast rice versus monacolin K alone on colon cancer cells. J. Nutr. Biochem. 2008, 19, 448–458. [Google Scholar] [CrossRef] [PubMed]
- Akihisa, T.; Tokuda, H.; Yasukawa, K.; Ukiya, M.; Kiyota, A.; Sakamoto, N.; Suzuki, T.; Tanabe, N.; Nishino, H. Azaphilones, Furanoisophthalides, and Amino Acids from the Extracts of Monascus pilosus-Fermented Rice (Red-Mold Rice) and Their Chemopreventive Effects. J. Agric. Food Chem. 2005, 53, 562–565. [Google Scholar] [CrossRef] [PubMed]
- Bogsrud, M.P.; Ose, L.; Langslet, G.; Ottestad, I.; Strøm, E.C.; Hagve, T.A.; Retterstøl, K. HypoCol (red yeast rice) lowers plasma cholesterol—A randomized placebo-controlled study. Scand. Cardiovasc. J. 2010, 44, 197–200. [Google Scholar] [CrossRef] [PubMed]
- Zhang, X.; Liu, W.; Chen, X.; Cai, J.; Wang, C.; He, W. Effects and mechanism of blue light on Monascus in liquid fermentation. Molecules 2017, 22, 385. [Google Scholar] [CrossRef] [PubMed]
- Fabio, A.D.; Parraga, G. Origin, production and utilization of pseudocereals. In Pseudocereals—Chemistry and Technology; Haros, C.M., Schoenlechner, R., Eds.; Wiley & Sons: New York, NY, USA, 2017; pp. 1–27. [Google Scholar]
- Patrovsky, M.; Sinovska, K.; Branska, B.; Patakova, P. Effect of initial pH, different nitrogen sources, and cultivation time on the production of yellow or orange Monascus purpureus pigments and the mycotoxin citrinin. Food Sci. Nutr. 2019, 7, 3494–3500. [Google Scholar] [CrossRef] [PubMed]

| Sources of Variation | Sum of Squares | Df | Mean Square | F-Ratio | p-Value |
|---|---|---|---|---|---|
| Main effects | |||||
| A: Supplement | 4227.09 | 6 | 704.515 | 28.12 | 0.0000 |
| B: Concentration (%) | 21.10 | 1 | 21.099 | 0.84 | 0.3611 |
| C: pH | 9.07 | 2 | 4.533 | 0.18 | 0.8348 |
| Interactions | |||||
| AB | 122.11 | 6 | 20.352 | 0.81 | 0.5630 |
| AC | 59.47 | 12 | 4.956 | 0.20 | 0.9983 |
| BC | 0.59 | 2 | 0.293 | 0.01 | 0.9884 |
| Residuals | 2405.39 | 96 | 25.056 | ||
| Total (Corrected) | 6844.82 | 125 |
| Supplement | Count | LS Mean | LS Sigma | Homogeneous Groups |
|---|---|---|---|---|
| Monosodium glutamate | 18 | 46.165 | 1.1798 | X |
| Fish hydrolysate | 18 | 52.421 | 1.1798 | X |
| Fish fermented | 18 | 53.342 | 1.1798 | X X |
| Fructose | 18 | 55.444 | 1.1798 | X X |
| Molasses | 18 | 57.147 | 1.1798 | X X |
| Glucose | 18 | 57.482 | 1.1798 | X |
| Sodium chloride | 18 | 66.766 | 1.1798 | X |
| Count: percentage of substrate (0.5, 1%) × pH (5, 6, 7) × three replicas; LS Mean: least squares mean; LS Sigma: least squares sigma. | ||||
| Glucose | Fructose | Molasses | Fermented Fish | Fish Hydrolysate | Monosodium Glutamate | Sodium Chloride | |
|---|---|---|---|---|---|---|---|
| 5 | ![]() | ![]() | ![]() | ![]() | ![]() | ![]() | ![]() |
| 6 | ![]() | ![]() | ![]() | ![]() | ![]() | ![]() | ![]() |
| 7 | ![]() | ![]() | ![]() | ![]() | ![]() | ![]() | ![]() |
Publisher’s Note: MDPI stays neutral with regard to jurisdictional claims in published maps and institutional affiliations. |
© 2022 by the authors. Licensee MDPI, Basel, Switzerland. This article is an open access article distributed under the terms and conditions of the Creative Commons Attribution (CC BY) license (https://creativecommons.org/licenses/by/4.0/).
Share and Cite
Quispe-Rivera, E.; Tucta-Huillca, F.; Gonzales-Barron, U.; Cadavez, V.; Silva-Jaimes, M.; Morales, J.J. Effect of Carbon, Nitrogen and Salt Sources on the Growth of Monascus purpureus in Quinoa (Chenopodium quinoa)-Based Culture Media. Biol. Life Sci. Forum 2022, 18, 64. https://doi.org/10.3390/Foods2022-12999
Quispe-Rivera E, Tucta-Huillca F, Gonzales-Barron U, Cadavez V, Silva-Jaimes M, Morales JJ. Effect of Carbon, Nitrogen and Salt Sources on the Growth of Monascus purpureus in Quinoa (Chenopodium quinoa)-Based Culture Media. Biology and Life Sciences Forum. 2022; 18(1):64. https://doi.org/10.3390/Foods2022-12999
Chicago/Turabian StyleQuispe-Rivera, Evelyn, Franz Tucta-Huillca, Ursula Gonzales-Barron, Vasco Cadavez, Marcial Silva-Jaimes, and Juan Juscamaita Morales. 2022. "Effect of Carbon, Nitrogen and Salt Sources on the Growth of Monascus purpureus in Quinoa (Chenopodium quinoa)-Based Culture Media" Biology and Life Sciences Forum 18, no. 1: 64. https://doi.org/10.3390/Foods2022-12999
APA StyleQuispe-Rivera, E., Tucta-Huillca, F., Gonzales-Barron, U., Cadavez, V., Silva-Jaimes, M., & Morales, J. J. (2022). Effect of Carbon, Nitrogen and Salt Sources on the Growth of Monascus purpureus in Quinoa (Chenopodium quinoa)-Based Culture Media. Biology and Life Sciences Forum, 18(1), 64. https://doi.org/10.3390/Foods2022-12999